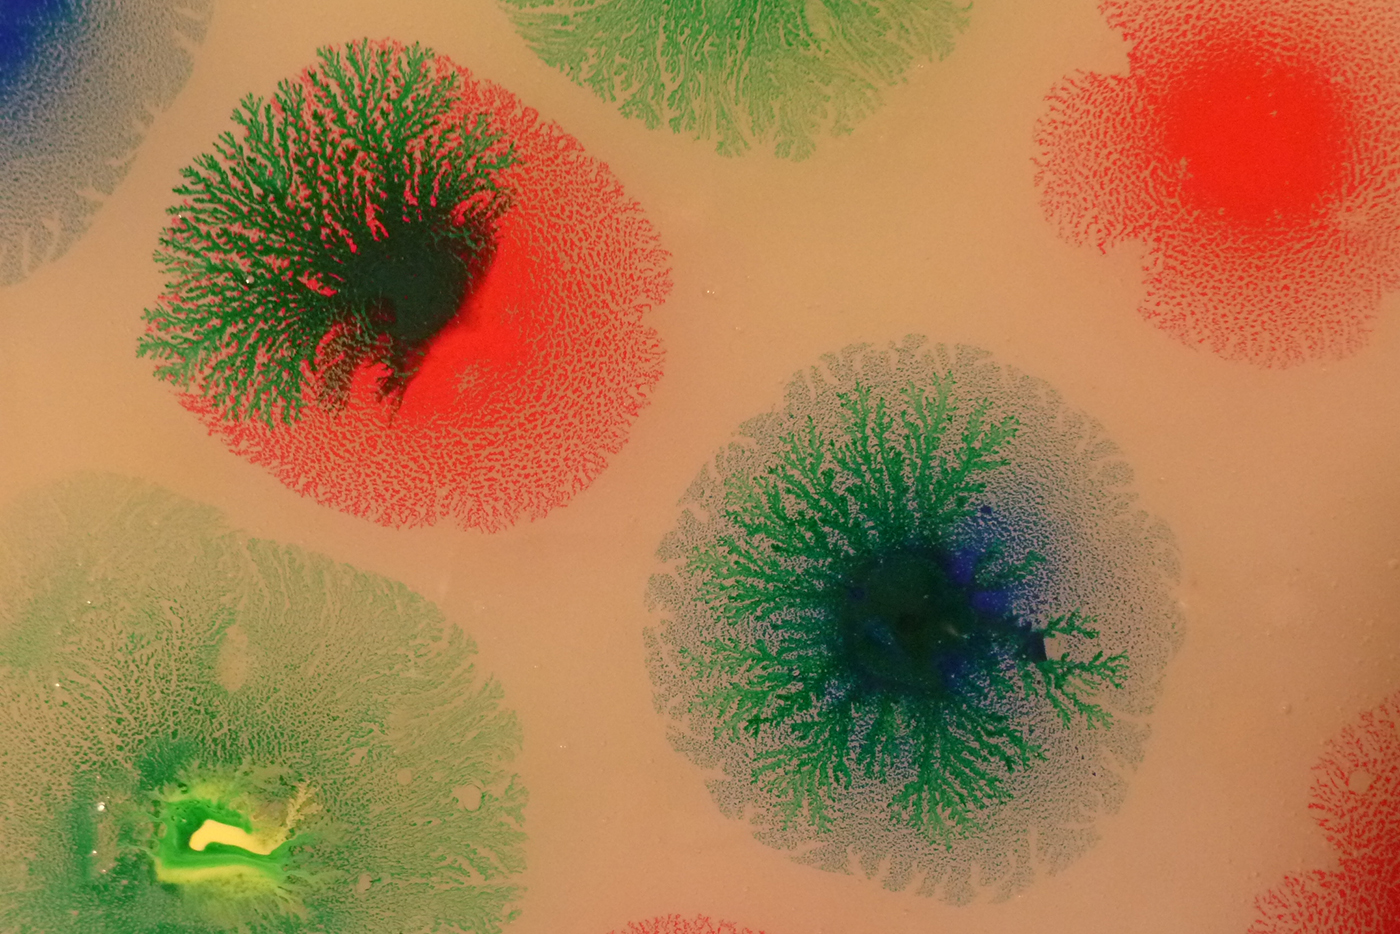
Colours

2013 - 2016
Contributors: ELODIE DESCOUBES/ DESIGNER, STÉPHANE SAUTOUR/ ARTIST
Succeeding in extending the action of colour, mobilising what makes it so fascinating and making a scientific culture activity of it is the challenge that F93 has set itself. Before taking a break, the team in charge of the project has drafted a final stage.
This project is not so much about using the techniques and mediations by which human beings render colours but rather the modes of action and presence of the colours themselves. Colours are active – the very opposite of passive beings. Under the effect of a colour, we can come together, learn, mobilise ourselves, visit or prepare ourselves. This is the principle that we are championing. To say that a colour is there is to characterise a unique mode of existence. We have observed this each time we were in contact with colours and making a point of being aware of the situation. The observation was not unsurprising for us and we wanted to make it an approach. Colours are part of what can be there without using extensive resources. In certain situations, a slight colour is enough to limit discussions or involve choices that require responses. Each of us can, then, be under the spell of a colour, or keep a certain distance or even relate to it with regard to the attention we might pay to the situation it has created. Because, above all, it is in the detail of these effects that one or several colours emerge, spread, demand extra attention or trigger a new engagement. When colour appears to escape, this is one effect among many – we have seen that it is never definitive – colour can dissolve or lose itself as quickly as it asserted itself, leaving everyone in a state of indecision, before suddenly re-emerging, sometimes even more distinct than before.
In the various workshops that we devised and then tested, colour sometimes made its presence felt at the beginning and at the end, only moving aside in the middle. At other times, it was present throughout and very strongly so, or, on the contrary, constantly hiding before suddenly emerging and causing the activity underway to fail. We multiplied the different strategies to make colour circulate around the workshops. Fabricated here, manipulated there, sometimes a trace, sometimes a representation – colour fluctuates between many different modalities. Though this fluctuation, and depending on the moment, it involved combining or selecting procedures to accumulate colours in the space of the workshop. The presence of the colour asserted itself there in tangible experiments that were sparked by a set of rules and markers. It must be thus with the presence of colour – neither backdrop nor irrelevant detail but the presence of a being, of its mark in space, which may, admittedly, be part of the totality of space, or make do with being a mere dot – but which, above all, is present, like a companion of whom we ask only to be there, and who asks for nothing in return.
Images of work: ELODIE DESCOUBES

Avec la période de confinement, les démarches initiées en collège ont connu quelques changements, également quelques aménagements et surprises. Le moment est venu de présenter ce qui a été finalisé par les élèves, les enseignants et les intervenants. Cet espace de diffusion rapporte nombre de témoignages visuels, sous des formats à la fois fixes et animés, et invite les visiteurs à une découverte différenciée : en cela par projet identifié ou d’une manière plus aléatoire.